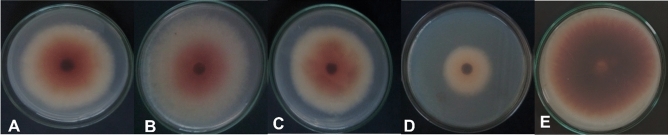
Figure 3

Abstract
This study was conducted to evaluate the ability of some fungal culture filtrate, as biocontrol agents against okra wilt caused by Fusarium solani. and Meloidogyne javanica. In the present study, fungal culture filtrates (FCFs) of Aspergillus terreus (1), Aspergillus terreus (2), Penicillium chrysogenum, and Trichoderma spp. were tested against M. javanica in vitro. The effects of P. chrysogenum and Trichoderma spp. (FCFs) in controlling root-rot fungi and root-knot nematode disease complex on okra plants were studied under greenhouse conditions (In vivo). In vitro experiment, the results revealed cumulative rate of J2s mortality of M. javanica reached to 97.67 and 95% by P. chrysogenum and Trichoderma spp., respectively, after 72 h. incubation. Additionally, Trichoderma spp exhibited the most effective inhibitory activity against the pathogen's radial growth, with a percentage of 68%. P. chrysogenum ranked second with 53.88%, while A. terreus (2) demonstrated the weakest inhibitory effect of 24.11%. T6 [Nematode infection (M. javanica) + Fungus infection (F. solani) + Overflowed with fungal culture filtrate (P. chrysogenum)] and T8 [Nematode infection (M. javanica) + Fungus infection (F. solani) + spray with fungal culture filtrate (P. chrysogenum)] had the greatest effects on nematode galling indices on okra roots and substantially reduced the reproductive factors in the greenhouse (In vivo experiment). T6 was the best treatment to decrease disease severity, as reached (28%) relatively. On the other hand, T12 [(Fungus infection (F. solani) + (Dovex 50% fungicide with irrigation water)] recorded the lowest disease severity reaching (8%) relatively. The results showed that nematode infection or fungus infection or both decreased all studied anatomical characteristics of okra root, stem, and leaves. We concluded from this study that root-knot nematode and root-rot fungi were reduced by using fungal culture filtrates and could improve plant growth.
Subject terms: Cell biology, Microbiology, Plant sciences, Stem cells, Structural biology
Introduction
Okra (Abelmoschus esculentus L.) Moench is a highly nutritious crop grown in regions with Mediterranean, tropical, and subtropical climates1. However, okra production is often hindered by a range of insect and disease problems, including root-knot nematodes (Meloidogyne spp.) and fungal pathogens2. These pests can significantly reduce crop yields, resulting in economic losses for farmers and food shortages for communities.
Plant-parasitic nematodes are among the most damaging pests of vegetable crops, accounting for significant global agricultural production losses each year3. Root-knot nematodes are the most common and commercially significant nematode pests, with a life cycle of 25 days at 27 °C4. Nematode and fungal infestations are considered the most important biotic factors that lower crop production, and nematodes can also predispose plants to secondary invasion by fungal diseases, exacerbating disease severity by modifying plant roots5.
Chemical control of nematodes and fungi is costly and has potential environmental and public health risks6,7. Therefore, developing safe and effective techniques for managing these harmful infections is essential. Biological control is a safer alternative to chemical nematicides, and Penicillium and Trichoderma fungi have a reputation for being hostile to plant-parasitic nematodes8,9. However, little is known about the mode of action of fungal culture filtrates (FCF) and their efficacy in controlling complex diseases caused by root-knot nematodes and rot-root fungi in okra plants.
In this study, we investigate the impact of biological control agents' strategy (fungal culture filtrates) in the control of the complex disease caused by the root-knot nematode and rot-root fungi. We also examine the mode of action of FCF on the morphological traits, anatomical analysis, and productivity of okra plants. Our study aims to contribute to the development of safe and effective techniques for the prevention and control of pathogenic agents in okra production.
Materials and methods
Isolation and identification of the causal pathogens
On Potato Dextrose Agar (PDA) medium, the causative pathogenic fungi were isolated using the agar plate technique10. Using the conventional hyphal tip approach, Fusarium spp. was isolated from the diseased Okra plants and introduced into pure culture11. To stop bacterial growth in the medium before sterilization, 250 mg L−1 of chloramphenicol (l-chloramphenicol) was added12. Utilizing either the single spore or hyphal tip procedures, the produced fungus were purified13. For subsequent studies, stock cultures were kept on PDA slants in a refrigerator at 5 °C. The physical characteristics of mycelia and spores, as described by Leslie and Summerell14 and Ismail, et al.15 were used to identify fungal isolates.
Isolation and identification of endophytic fungi
The modified approach developed by Hallmann, et al.16 was used to isolate endophytic fungi. The obtained root and branch samples were carefully cleaned with sterile distilled water after being washed with mild detergent and running tap water to get rid of the dirt particles and adherent debris. For one minute, 70% ethanol was used to surface sterilize the samples. The samples were submerged in 4% sodium hypochlorite for 3 min to thoroughly sterilize the surfaces and get rid of any clinging germs. The samples were then dried on sterile filter paper after being washed with sterile distilled water. Using a sterile scalpel, the samples were divided into 5–10 mm pieces and grown in Petri plates with PDA media supplemented with chloramphenicol (250 mg L–1) to inhibit bacterial growth. Petri plates were covered with parafilm, incubated for 15 days at 27 ± 2 °C in the dark, and daily checked. Separate transfers of the purified endophytic fungal isolates to PDA slants were made. Finally, all the purified endophytic fungi were stored at 4 °C until further use. According to Domsch et al.17, Domsch et al.18, endophytic fungus isolates were recognized at the Assiut University Moubasher Mycological Center (AUMMC), Assiut, Egypt based on their macro- and microscopic features. Endophytic fungi P. chrysogenum and Trichoderma spp. were grown on potato dextrose broth (PDB) and incubated at 25 °C for 21 days, then filtered through sterilized cheesecloth to remove mycelium mats, then filtered through Membrane Solutions MS CA Syringe Filter (0.45 μm) to obtain cell-free culture filtrates then kept in freezer (at 5 °C) as stander solutions until use.
Nematode inoculums
A pure culture of M. javanica was grown from a single egg mass removed from infected okra roots and kept alive on tomato cv. Strian-B in greenhouse. The whole root system of infected plants was dipped in water and carefully cleaned to eliminate any clinging dirt before being uprooted from the soil. Forceps were used to remove egg masses, which were subsequently cleaned with sterile water, put in a 0.5% sodium hypochlorite (NaOCl) solution, stirred for four minutes, and then dried on a 26 µm sieve19. A modified version of Baermann funnel technique was used to incubate the eggs for 3–5 days in order to produce second-stage juveniles (J2) for in vitro and pot studies20.
In vitro experiment
Evaluation of fungal culture filtrates on M. javanica mortality
The assessment was done in 5 cm clean Petri dishes. As a control, Petri plates filled with distilled water were used. A. terreus (1), A. terreus (2), P. chrysogenum, and Trichoderma spp. fungal culture filtrates of concentration S/5 were prepared by adding 5 mL of distilled water to 1 mL of standard concentration "S" to study the juvenile’s mortality. One hundred from second stage (J2) of M. javanica were used in the study. Three replications of each treatment were used. All dead and alive (J2) were counted after 72 h of incubation to determine the proportion of J2 mortality.
Evaluation of fungal culture filtrates on F. solani radial colony growth
The study aimed to evaluate the effectiveness of culture filtrates derived from endophytic fungi in controlling F. solani. To achieve this, sterilized Petri dishes were filled with culture filtrates of A. terreus (1), A. terreus (2), P. chrysogenum, and Trichoderma spp., all at a 10% concentration (v/v). The PDA medium was allowed to solidify before placing 6 mm diameter mycelia discs of F. solani obtained from actively growing colonies in the center of the solidified agar plates. The control group was treated with sterilized distilled water instead of culture filtrate. The Petri dishes were then incubated at 25 ± 2 °C for four days, after which the percentage of inhibition in radial colony growth was calculated by comparing the results with the control group. The percent inhibition of mycelia growth of the pathogens was calculated using the following formula21.
where, D1 = colony diameter in control plate and D2 = colony diameter in treated plate.
Greenhouse test
The plant experiments complied with local and national regulations and followed the rules of the Al-Azhar University Assiut branch (Assiut, Egypt). We have permission that our studies have complied with the relevant institutional, national, and international guidelines and legislation. The studies were conducted at the experimental greenhouse of Plant Pathology Department, Faculty of Agriculture, Al-Azhar University Assiut branch (27°12′16.67′′ N; 31°09′36.86′′ E). Okra seeds of the cultivar OH-102 were sterilized for 3 min with 1% sodium hypochlorite, then gently rinsed with sterilized distilled water, followed by thorough drying. Silt and clay soil that had been formalin-disinfested were mixed in a ratio of one to one in 25 cm diameter plastic pots. On autoclaved sand barley medium, inocula of F. solani were produced by cultivating the required causative pathogenic fungus at 25 °C for 2 weeks. The prepared inoculum was mixed thoroughly with the potted soil before plantingat a rate of 3% weight and left for a week. As a control, potted soil was combined at the same rate with pathogen-free sterilized sand barley. Okra seeds that had been surface sterilized and appeared to be in good condition were sown in pots at a rate of four seeds per pot. Each treatment utilized five replicated pots. The okra plants were injected with 3000 freshly hatched juveniles derived from the pure culture of M. javanica two weeks after planting. The necessary quantity of nematode suspension was injected into three holes drilled around the plants to perform the inoculation. To keep the holes from drying out, the soil was placed over them.
Experimental design and treatments
The experiment was carried out in a randomized complete block design. The treatments for the experiment were:
T1 [Nematode infection (M. javanica)].
T2 [Nematode infection (M. javanica) + Overflowed with fungal culture filtrate (P. chrysogenum)].
T3 [Nematode infection (M. javanica) + Overflowed with fungal culture filtrate (Trichoderma spp.)].
T4 [Nematode infection (M. javanica) + (Oxamyl 24% pesticide with irrigation water)].
T5 [Nematode infection (M. javanica) + Fungus infection (F. solani)].
T6 [Nematode infection (M. javanica) + Fungus infection (F. solani) + Overflowed with fungal culture filtrate (P. chrysogenum)].
T7 [Nematode infection (M. javanica) + Fungus infection (F. solani) + Overflowed with fungal culture filtrate (Trichoderma spp.)].
T8 [Nematode infection (M. javanica) + Fungus infection (F. solani) + spray with fungal culture filtrate (P. chrysogenum)].
T9 [Nematode infection (M. javanica) + Fungus infection (F. solani) + spray with fungal culture filtrate (Trichoderma spp.)].
T10 [Fungus infection (F. solani) + Overflowed with fungal culture filtrate (Trichoderma spp.)].
T11 [Fungus infection (F. solani) + Overflowed with fungal culture filtrate (P. chrysogenum)].
T12 [(Fungus infection (F. solani) + (Dovex 50% fungicide with irrigation water)].
T13 Fungus infection (F. solani).
T14 [Control (untreated)].
Fungal culture filtrates (FCFs) were applied to plants as overflowed or sprayed onto leaf surface four days after inoculation by nematode (two weeks after planting). Oxamyl 24% and Dovex 50% were applied in the dose recommended by the manufacturer for resistance to nematodes and Fungus, respectively.
During the experiment, crop measurements (the number of fruits, fruit length, and fruit weight) every 3 days were estimated. After 8 weeks after inoculation, the plants were carefully uprooted from the soil and measured for shoot length, root length, plant weight, stem diameter, number of branches, leaf area, and leaf number. Additionally, the number of galls, egg-masses/root, and eggs/egg-mass were counted. The ultimate nematode population and nematode reproduction rate were estimated.
According to Abdel-Razik, et al.22, the Fusarium wilt disease severity (%) was determined after 60 days had passed since planting using the disease severity (DS) scale (0:5), which indicated [0 = no visible symptoms; 1 = slight vein-clearing and chlorosis of the leaves; 2 = yellowing and wilting of lower leaves and extend to upper leaves; 3 = brown (discoloration) of the vascular systems of tap rot and stem; 4 = indicates necrotic streaks on the stem base that extend toward the apex, while 5 = indicates an early plant demise. The following equation was used to calculate the percentage of disease severity index (DSI) for each tested isolate:
where (d) is the overall disease rating for each plant, (d max) is the maximum disease rating, (n) is the total number of plants tested in each duplicate.
Anatomical study
At 60 days following planting, a comparative anatomical investigation of the root, stem, and leaf of treated and control okra plants was conducted. Okra root, stem, and terminal leaf samples were gathered. The samples of stem and leaf were obtained from the 5th apical internode of the main stem and its corresponding leaf with the most successful treatments, i.e., T1, T5, T6, T7, and T13, in addition to those of the control (T14) after 60 days. The root tips were sampled at a distance of 0.5 cm. The samples were collected, killed, and preserved in a solution containing (5 mL formalin, 10 mL glacial acetic acid, and 85 mL 70% ethanol). It was then washed in 50% ethyl alcohol, dehydrated in a succession of ethyl alcohols (50, 70, 80, 90, 95, and 100%), infiltrated in xylene, embedded in paraffin wax with a melting temperature of 40–45 °C, sectioned on a rotary microtome at a thickness of 5–7 m, dyed with the double stain procedure (light green and safranin), cleared in xylene and mounted in Canada balsam23. Sections were examined to look for histological evidence of treatment-related noticeable responses. The prepared sections were examined under a microscope and counts and measurements (µ) were taken using computerized morphometrical analysis. This analysis was carried out using a Research Microscope type Axiostar plus manufactured by Zeiss that was upgraded to be able to use a professional digital image analysis system (Carl Zeiss Axiovision Product Suite DVD 30).
The following measurements were recorded: 1—Anatomical features of okra root: root diameter (Ø of root); cortex thickness; diameter of vascular cylinder (Ø of V.C); length of xylem arch. 2—Anatomical features of okra stem: stem diameter (Ø of stem); cortex thickness; diameter of vascular cylinder (Ø of V.C); vascular bundle thickness (V.B. thickness); pith thickness. 3—Anatomical features of okra leaf: thickness of leaf midrib; spongy tissue thickness; palisade tissue thickness; vascular bundle thickness (V.B. thickness).
Statistical analysis
Three to four duplicate experiments were run for each treatment to satisfy the random design. One-way analysis of variance (ANOVA), which was performed using the software (Statistix 8.1) for statistical analysis of the experiment's results, was used to analyze the growth parameters and yield and assess for significance. To look at the variations between the means that were statistically significant, Duncan's multiple range tests with 95% confidence were performed24.
Statement permission
The authors declare that they have proper permission.
Results
In vitro experiment
Effect of FCFs on root-knot nematode
The fungal culture filtrates (FCFs) of A. terreus (1), A. terreus (2), P. chrysogenum and Trichoderma spp. were tested for their nematicidal effect on second stage juveniles of M. javanica in vitro (Fig. 1). The results revealed that the nematode mortalities with fungal culture filtrates were increased with the increase of the exposure time from 24 to 72 h (FCF) of Trichoderma spp. was more effective against M. javanica J2 followed by P. chrysogenum with mortality rates (97.67 & 95%), respectively, after 72 h of exposure time.
Figure 1.
Effect of four fungal culture filtrates (FCFs) on mortality percentage of M. javanica J2 under laboratory conditions.
Effect of FCFs on F. solani radial colony growth
An experiment was conducted in a laboratory to investigate the efficacy of fungal culture filtrates (FCFs) derived from endophytic fungi at a 10% concentration (v/v) as biocontrol agents against F. solani. The study involved testing the FCFs of A. terreus (1) and A. terreus (2), P. chrysogenum, and Trichoderma spp. against the causal pathogen (as shown in Figs. 2 and 3A–E). The results revealed that the FCFs inhibited the growth of the pathogen with varying degrees of effectiveness. Treatment with FCFs of these antagonistic fungi significantly reduced the linear growth of the tested pathogen compared to the control (distilled water). Notably, Trichoderma spp (Fig. 3D) showed the highest percent inhibition of radial growth of the causal pathogen (68%), followed by P. chrysogenum (53.88%) (Fig. 3C). In contrast, A. terreus (2) had the lowest inhibitory effect (24.11%) (Fig. 3B).
Figure 2.
Effect of four fungal culture filtrates (FCFs) on F. solani radial growth under laboratory conditions after four days.
Figure 3.
Antifungal activity of endophytic fungi culture filtrates against the causal pathogen F. solani. Where: (A) A. terreus (1); (B) A. terreus (2); (C) P. chrysogenum; (D) Trichoderma spp.; and (E) control.
Greenhouse experiment
Effect of fungal culture filtrates (FCFs) on root-rot fungus and root-knot nematode under greenhouse conditions
The effects of P. chrysogenum (FCFP) and Trichoderma spp. (FCFT) applied as foliar spray and soil drenches on control of root-rot fungus (F. solani) and root-knot nematode (M. javanica) disease complex on growth and anatomical characteristics of okra plants cv. OH-102 were studied under greenhouse conditions. Data presented in Table 1 and Fig. 4 showed that, all applications of the tested (FCFs) significantly reduced the values of root galls per root and nematode reproduction on roots of okra when compared with untreated plants [control (T14). Therefore, (FCFP) as soil drenches (T4) and foliar sprays (T8) caused the lowest gall numbers (40 and 49)], respectively. While (FCFP) as soil drenches (T4) and foliar sprays (T8) caused the lowest rate of nematode reproductions (2.32 and 4.42), respectively. On the other hand, plants inoculated with T1 recorded the highest number of galls and rates of nematode reproductions (170 and 21.20, respectively) followed by T5 (143 and 16.75, respectively). The highest values of the final nematode population and number of galls were under T1, while the lowest values of the final nematode population and number of galls were under T4.
Table 1.
Effect of spray or overflowed of P. chrysogenum (FCFP) and Trichoderma spp. (FCFT) against root-knot nematode or/and root-rot fungi infecting okra under greenhouses condition.
| Treatments | No. galls | Nematode population | Fungal disease severity (%) | ||
|---|---|---|---|---|---|
| No. of eggs/egg-mass/root system | Nematode final population (Pf) | Rate of nematode reproduction (Pf/PI) | |||
| T1 | 170a | 411a | 63,611 | 21.20 | 48 |
| T2 | 50def | 298b | 14,243 | 4.75 | 36 |
| T3 | 76c | 323b | 23,518 | 7.84 | 40 |
| T4 | 40g | 174c | 6969 | 2.32 | 36 |
| T5 | 143b | 365eb | 50,248 | 16.75 | 60 |
| T6 | 54def | 311b | 16,743 | 5.58 | 28 |
| T7 | 68cd | 308b | 20,378 | 6.79 | 36 |
| T8 | 49fg | 277b | 13,255 | 4.42 | 36 |
| T9 | 63cde | 301b | 18,673 | 6.22 | 40 |
| T10 | – | – | – | – | 32 |
| T11 | – | – | – | – | 48 |
| T12 | – | – | – | – | 8 |
| T13 | – | – | – | – | 36 |
| T14 | – | – | – | – | 00 |
Means in each column followed by the same letters are not significantly different by (p = 0.05) according to Duncan's multiple range test. For more details about the treatments see experimental design and treatments section. Where rate of nematode reproduction = final population (Pf)/initial population (PI); final population (Pf) = larva in soil + developmental stages + adult female + (number of egg-masses × eggs); initial population (PI) was 3000 s stage larva (J2) of root knot nematode (M. javanica).
Figure 4.
An illustration of the effect of spray or overflowed of P. chrysogenum (FCFP) and Trichoderma spp. (FCFT) infected with root-knot nematode or/and root-rot fungi infecting okra under greenhouses condition.
Data presented in Table 1 indicate that F. solani was able to infect okra plants causing root rot with varied degrees. Therefore, T5 caused the highest disease severity (60%) followed by T1 and T11 (48%). While the disease severity of T3 and T9 observed the same disease severity (40%) relatively. On the other hand, T6 were recorded the lowest disease severity as reached (28%) relatively followed by T12 (8%).
Morphological characteristics
Plant metrics were offered lowest significant, under the circumstances of single nematode infection, single fungal infection, or both of them together (Table 2). Generally, application of the fungal culture filtrates (FCFP, T) resulted in a significant increase in most of the measured traits, whether it was a spraying system or overflowed, the tallest shoot recorded by T12 and T8 were (42.71 and 42.64 cm), respectively, while the shortest shoot length observed under T5 with (21.51 cm). The characteristic of root length was significantly higher by spraying (FCFT, P) at treat nematode and fungal infection under T8, T9, and T12 were (34.81, 35.82, and 35.94 cm), respectively, and the lowest significant value noted at nematode and fungal infection T5 (19.1 cm). The biggest plant weight watched under T12 and T11 (49 and 48.33 g.) as well as the smallest weight mentioned was 16.67 g. with nematode and fungal infection (T5). Several significant were recognized in stem diameter, and the highest rang listed by (FCFP) applied as a spray on treatment nematode and fungal infection (T8) was 1.43 mm, whereas the less rang was 0.76 mm for nematode infection (T1). Branches number trait presented various significance, T4, T8, and T9 led to the highest number of branches (5.00, 4.33, and 4.33), respectively, however, the lowest number of branches noted at treat nematode and fungal infection (T5) was (2.00). Although the treatment T12 (Fungicide) was the highest treatment that recorded the highest leaves area (40.69 cm2), there was no significant difference between it and the application of the (FCFP) as overflowed for nematode and fungal infection (T6) and (FCFT) as a foliar spray (T9) where were 39.67 and 37.90 cm2, respectively, and the minimum leaves area was 16.41 cm2 by fungal infection (T1). Although the treatment T12 (Fungicide) was the highest treatment that recorded the highest leaves number (19.33), there was no significant difference between it and the application of the (FCFP) as overflowed to treat fungal alone (T11) and nematode alone (T2) had greater leaves number were 16.67 and 15.67, respectively, while the lowest leaves number was 3.67 under T1. Else, there were no significant differences between T12 [(Fungus infection (F. solani) + (Dovex 50% fungicide with irrigation water)] and T9 [Nematode infection (M. javanica) + Fungus infection (F. solani) + spray with fungal culture filtrate (Trichoderma spp.)] in the yield of fruits, as the yield of fruits was 34.77 g plant−1 under T12 and under T9 was 33.27 g plant−1.
Table 2.
Effect of spray or overflowed of P. chrysogenum (FCFP) and Trichoderma spp. (FCFT) on plant growth parameters of okra plant under greenhouse conditions infected with root-knot nematode or/and root-rot fungi infecting.
| Treatments | Shoot length (cm) | Root length (cm) | Plant weight (g) | Stem diameter (mm) | No. branches | Leaves area (cm2) | No. of leaves | Fruit yield (g) plant−1 | No fruits plant−1 | Fruit length (cm) | Fruit weight (g) |
|---|---|---|---|---|---|---|---|---|---|---|---|
| T1 | 24.87def | 24.97ab | 21cd | 0.76d | 2.33cd | 16.41ef | 3.67f | 31.83abc | 3.00b | 9.37ab | 9.50abc |
| T2 | 31.63b-e | 26.10ab | 40ab | 1.15abc | 3.67a-d | 25.52cde | 15.67ab | 21.47ef | 3.00b | 9.30ab | 9.20bcd |
| T3 | 26.66cdef | 25.46ab | 21.67cd | 0.92cd | 2.33cd | 26.18cde | 8.33def | 24.23def | 3.00b | 8.73ab | 8.07cde |
| T4 | 33.59a-d | 27.87ab | 42.33ab | 1.13abc | 5.00a | 29.42bcd | 15.33ab | 30.03a-d | 3.00b | 9.93a | 10.03ab |
| T5 | 21.51f | 19.16b | 16.67d | 0.90cd | 2.00d | 12.72f | 6.67ef | 27.63b-e | 3.00b | 7.93b | 7.17e |
| T6 | 32.56a-e | 26.41ab | 34.67abc | 1.14abc | 4.00abc | 39.67ab | 12.00bcd | 32.37abc | 3.00b | 9.77a | 11.13a |
| T7 | 31.32b-f | 29.19ab | 33.33bc | 1.11abc | 4.00abc | 32.71abc | 10.33cde | 27.67b-e | 3.00b | 8.93ab | 9.23bcd |
| T8 | 42.64a | 34.81a | 42.67ab | 1.43a | 4.33ab | 34.11abc | 14.00bc | 25.83c-f | 3.00b | 9.30ab | 9.67abc |
| T9 | 36.63abc | 35.82a | 43.00ab | 1.05bcd | 4.33ab | 37.90ab | 14.00bc | 33.27ab | 4.00a | 9.53ab | 10.43ab |
| T10 | 22.74ef | 27.79ab | 30.00bcd | 0.96cd | 2.33cd | 18.51def | 9.33cde | 23.03ef | 3.00b | 8.50ab | 10.00ab |
| T11 | 38.86ab | 28.91ab | 48.33a | 1.17abc | 3.67a-d | 28.49bcd | 16.67ab | 32.50abc | 3.33ab | 9.60a | 7.67de |
| T12 | 42.71a | 35.94a | 49.00a | 1.31ab | 3.00bcd | 40.69a | 19.33a | 34.77a | 3.00b | 9.40ab | 7.80 de |
| T13 | 32.43a-e | 26.44ab | 29.67bcd | 1.08bcd | 2.33cd | 23.46cde | 6.67ef | 19.97f | 3.00b | 8.43ab | 7.50 de |
| T14 | 33.55a-d | 28.48ab | 35abc | 1.09bc | 2.67bcd | 33.32abc | 7.00ef | 23.40ef | 4.00a | 8.87ab | 7.80 de |
Means in each column followed by the same letters are not significantly different by (p = 0.05) according to Duncan's multiple range test. For more details about the treatments see experimental design and treatments section.
In this study, the (FCFT) as a foliar spray for nematode and fungal infection combined (T9) equal in the number of fruits with control treatment (T14). The greatest increase of fruit length was under T4 (9.93 cm) followed by (FCFP) as overflowed with treated nematode and fungal infection together and fungal infection T6 (9.77 cm), as well the lowest value was reported by nematode and fungal infection treatment T5 (7.93 cm). Application of the (FCFP) as overflowed with nematode and fungal infection combined (T6) achieved the weight of the fruits (11.13 g), followed by (FCFT) treat as a foliar spray with nematode and fungal infection combined T9 (10.43 g), while the lowest values noted by nematode and fungal infection treatment T5 (7.17 g).
Anatomical studies
The Anatomical studies to follow up the internal structure changes, which exhibited the most noticeable response against root-knot nematode, root-rot fungi, and fungal culture filtrate of P. chrysogenum applied as overflowed or foliar spray and their effect on the mean counts and measurements in micron (μ) of certain histological features of root, stem and leaf of okra grown in the plastic pots at 60 days after sowing based on transverse sections.
Data in Table 3 and Figs. 3, 4 and 5 obviously indicate the effect of different applied treatments: T1 [Nematode infection (M. javanica)], T5 [Nematode infection (M. javanica) + Fungus infection (F. solani)], T6 [Nematode infection (M. javanica) + Fungus infection (F. solani) + Overflowed with fungal culture filtrate (P. chrysogenum)], T7 [Nematode infection (M. javanica) + Fungus infection (F. solani) + Overflowed with fungal culture filtrate (Trichoderma spp.)], T13 [Fungus infection (F. solani)], and on different anatomical features of okra root, stem and leaves compared with untreated plants (T14). In current study, most of these applied treatments have a positively impact on most studied histological characteristics of different okra organs i.e., root (Ø of root, cortex thickness, Ø of V.C and length of xylem arch), for stem (Ø of stem, cortex thickness, Ø of V.C and V.B thickness) as well as leaves (spongy and palisade tissues thickness and V.B thickness).
Table 3.
Anatomical characteristics of P. chrysogenum fungal culture filtrate (FCFP) against M. javanica and F. solani on okra root, stem and leaf under greenhouse conditions.
| Treatment | Root anatomical | Stem anatomical | Leaves anatomical | ||||||
|---|---|---|---|---|---|---|---|---|---|
| Ø of root (µm) | Ø of V.C (µm) | Xylem arm length (µm) | Ø of stem (µm) | Ø of V.C (µm) | V.B. thickness (µm) | Palsied tissue thickness (µm) | spongy tissue thickness (µm) | V.B. thickness (µm) | |
| T1 | 2951.79c | 1621.39c | 801.67bc | 4317.11c | 3073.24d | 445.48c | 143.51d | 133.29c | 193.14d |
| T5 | 2790.21d | 1558.87d | 741.27c | 3807.31e | 2807.99f | 284.23e | 141.79d | 127.85c | 170.67f |
| T6 | 3112.5b | 1674.43b | 804.16c | 4325.69c | 3211.79c | 486.01b | 167.08c | 145.71b | 205.11c |
| T7 | 3116.71b | 1702.66b | 837.38b | 4474.02b | 3346.29b | 489.67a | 193.41b | 163.26a | 224.96b |
| T13 | 2920.22c | 1620.12c | 773.48bc | 3968.18d | 2917.05c | 334.07d | 142.64d | 128.53c | 185.81e |
| T14 | 3400.54a | 2163.78a | 1276.26a | 4625.94a | 3532.19a | 510.81a | 201.89a | 169.79a | 271.79a |
| L.S.D. 5% | 45.66 | 43.90 | 79.73 | 51.03 | 37.47 | 11.20 | 7.60 | 11.87 | 6.46 |
Where: T1 = [Nematode infection (M. javanica)]; T5 = [Nematode infection (M. javanica) + Fungus infection (F. solani)]; T6 = [Nematode infection (M. javanica) + Fungus infection (F. solani) + Overflowed with fungal culture filtrate (P. chrysogenum)]; T7 = [Nematode infection (M. javanica) + Fungus infection (F. solani) + Overflowed with fungal culture filtrate (Trichoderma spp.)]; T13 = Fungus infection (F. solani); T14 = [Control (untreated)].
Figure 5.
Transverse sections (×12.5) of okra roots at 60 days after sowing as affected by different applied treatments. Where: T1 = [Nematode infection (M. javanica)]; T5 = [Nematode infection (M. javanica) + Fungus infection (F. solani)]; T6 = [Nematode infection (M. javanica) + Fungus infection (F. solani) + Overflowed with fungal culture filtrate (P. chrysogenum)]; T7 = [Nematode infection (M. javanica) + Fungus infection (F. solani) + Overflowed with fungal culture filtrate (Trichoderma spp.)]; T13 = Fungus infection (F. solani); T14 = [Control (untreated)]; Ep epidermis, Co cortex tissue, Ph phloem tissue, Xy xylem tissue.
The obtained results clearly showed that the application of T7 [Nematode infection (M. javanica) + Fungus infection (F. solani) + Overflowed with fungal culture filtrate (Trichoderma spp.)] and T6 [Nematode infection (M. javanica) + Fungus infection (F. solani) + Overflowed with fungal culture filtrate (P. chrysogenum)] treatments recorded the highest values of studied anatomical characteristics after untreated treatment (T14) compared with other applied treatments.
Root anatomy
In the present investigation, the treatments for nematode infection (T1), fungi infection (T13), or nematode infection + fungus infection (T5) lowered the morphological characteristics of the okra root most when compared to the control (T14), T6, and T7. The obtained findings are shown in Table 3 and Fig. 5. Numerous anatomical characteristics, particularly the T5, saw obvious reductions in their thickness. Since it had the most adverse impact on the anatomical traits that had been evaluated. The most significant anatomical characteristics were i.e., Ø of root (µm), Ø of V.C(µm), and Xylem arm length (µm), where all of them were significantly reduced with T5 compared with control (T14) and T7.
It's interesting to notice that the treatments' good effects on many anatomical characteristics were entirely undone when the treated plants' vegetative and reproductive development was increased, particularly in the cases of the control (T14) and (T7) treatments when compared to other treatments. The current investigation demonstrated increases in both xylem tissue, which is responsible for transporting various assimilates from leaves to fruits and other plant sinks, and phloem tissue, which is responsible for transporting water and mineral nutrients from roots to leaves. Therefore, the increase in the ultimate fruit yield might be directly attributed to the improvement of translocation events.
Stem anatomy
The obtained results in Table 3 and Fig. 6 show that, the treatments of nematode infection (T1) or fungi infection (T13) or nematode infection + fungus infection (T5) in the present study decreased the most of okra stem anatomical features compared with the (T14), T6, and T7. Okra plants with control (T14) and T7 appeared to be the most effective treatment. This treatment manifested the best results as it exceeded that of nematode infection + fungus infection (T5) in terms of most studied anatomical features. With regard to the stem diameter, it was reached its maximum value (3807.31 eμ) with nematode infection + fungus infection (T5), comparing with other treatments. Application treatments of control (T14) and T7 recorded highly values of the stem studied anatomical characteristics especially, in the Ø of root (µm), Ø of V.C (µm)and xylem arm length (µm) compared with other applied treatments.
Figure 6.
Transverse sections (×12.5) of okra stems at 60 days after sowing as affected by different applied treatments. Where: T1 = [Nematode infection (M. javanica)]; T5 = [Nematode infection (M. javanica) + Fungus infection (F. solani)]; T6 = [Nematode infection (M. javanica) + Fungus infection (F. solani) + Overflowed with fungal culture filtrate (P. chrysogenum)]; T7 = [Nematode infection (M. javanica) + Fungus infection (F. solani) + Overflowed with fungal culture filtrate (Trichoderma spp.)]; T13 = Fungus infection (F. solani); T14 = [Control (untreated)]; Ep epidermis, Co cortex tissue, Ph phloem tissue, Xy xylem tissue, Pi pith tissue.
It's interesting to notice that improving the vegetative and reproductive development of treated plants fully reversed these beneficial responses of various anatomical characteristics to treatments, particularly in the case of control (T14) and T7 compared to other treatments. The current investigation therefore demonstrated such expansions of xylem tissue, or the conduit of various assimilates from leaves to fruits and other plant sinks, and phloem tissue, or the route of water and mineral nutrient translocation from roots to leaves. As a result, an increase in the ultimate fruit production might be directly attributed to better translocation occurrences.
Leaf anatomy
The information in Table 3 and Fig. 7 demonstrated how the examined histological characteristics of the leaf reacted similarly to the anatomical characteristics of the stem. For mesophyll tissue, the application of M. javanica (T1), F. solani (T13), and M. javanica + F. solani had a significant impact on the thickness of both the spongy and palisade tissues (T5). Here, spongy tissue thickness value was decreased (127.85 cμ) with T5 but increased to reach (133.29 cμ) and (128.53 cμ) with T1 and T13, respectively, which were the more effective treatments in the same order. By contrast, palisade tissue thickness was (143.51 d and 142.64 dμ) with T1 and T13, respectively, but decreased to reach (141.79 dμ) with T5. With regard to V.B. thickness (µm) was reached their maximum values with T5 treatment. Here, V.B. thickness (µm) was decreased (170.67 fμ) with T5 while increased to reach (193.14 d) and (185.81 eμ) with T1 and T13, respectively, which were the more effective treatments in the same order.
Figure 7.
Transverse sections (×100) of Okra leaves at 60 days after sowing as affected by different applied treatments. Where: T1 = [Nematode infection (M. javanica)]; T5 = [Nematode infection (M. javanica) + Fungus infection (F. solani)]; T6 = [Nematode infection (M. javanica) + Fungus infection (F. solani) + Overflowed with fungal culture filtrate (P. chrysogenum)]; T7 = [Nematode infection (M. javanica) + Fungus infection (F. solani) + Overflowed with fungal culture filtrate (Trichoderma spp.)]; T13 = Fungus infection (F. solani); T14 = [Control (untreated)]; Ue upper epidermis, le lower epidermis, ph phloem tissue, xy xylem tissue.
The acquired results generally show that administered therapies, particularly T6 and T7, play a protective defensive function as resistance-inducers against detrimental effects by improving anatomical performance and metabolic defense system. The data indicated that, clearly indicate that applied treatments especially, control (T14), T6 and T7 play a defensive protective role as resistance -inducers against adverse effects by enhancing the anatomical performance and metabolically defense system had a positive effect on all studied anatomical characteristics of root (Ø of root, cortex thickness, Ø of V.C and length of xylem arch), for stem (Ø of stem, cortex thickness, Ø of V.C and V.B thickness) as well as leaves (spongy and palisade tissues thickness and V.B thickness). While the used treatments of T1 and T13 had a negative effect on most of the studied anatomical characteristics of root, stem and leaf of of okra plants compared with unstressed plants treatments. These decreases were more pronounced with M. javanica (T1), F. solani (T13), and M. javanica + F. solani (T5).
Discussion
The biocontrol potential of P. chrysogenum and Trichoderma spp. against root knot nematodes and Fusarium spp. was further confirmed by both laboratory and pot trial results. Trichoderma spp. species have been reported to suppress Fusarium spp. and plant parasitic nematodes25–27 due to their ability to produce hydrolytic enzymes that break down chitin in fungal cell walls28 as well as antibiotics29. Trichoderma spp. can directly control root-knot nematodes by producing poisonous compounds that prevent their penetration and growth30–32. For instance, T. viride and T. harzianum reduced the population of M. javanica in okra33,34 and tomato plants35–37. Their destructive activities include enzymatic disruption of eggshells and larval cuticles, as well as physiological abnormalities resulting from the production of diffusible toxic metabolites38,39. Studies by Sankari Meena, et al.40 and Poveda, et al.41 reported that the use of T. harzianum resulted in improved plant development metrics and a reduction in the fungal-nematode disease complex. Additionally, T. harzianum has been found to induce plant resistance and promote plant growth42.
Nematotoxic properties of diverse fungi's fungal culture filtrates add a new level of phytonematode biocontrol. Fungal culture filtrate of T. harzianum has been shown to have nematotoxic effects43, Alternaria alternata, A. flavus, P. chrysogenum, Rhizoctonia bataticola, T. viride have been recorded by Kumar, et al.44.
By decreasing the pathogen's development by up to 60.4%, the culture filtrate from T. harzianum displays antifungal action against F. oxysporum and confers resistance in soybean against F. oxysporum45. Bean pathogen growth can be inhibited by T. harzianum culture filtrate. In Phaseolus vulgaris seeds, Pythium ultimum lessens disease symptoms brought on by this pathogen46. The chitinase activity of cell-free culture filtrates improved, and they demonstrated fungus growth inhibition against the pathogens Dematophora necatrix, F. solani, F. oxysporum, and Pythium aphanidermatum. The effect was concentration-dependent, with the maximum growth inhibition rate for all the pathogens tested occurring at a concentration of 25% of the filtrate28.
The disease severity (%) dramatically decreased after the application of fungal culture filtrates, and plant growth metrics enhanced. These outcomes are consistent with those attained by Hegazy, et al.47 in sesame plants and Herrera-Téllez, et al.48 in tomato plants. Also, inhibition of mycelial growth by cultural filtrates of various bioagents49.
Microorganisms can produce certain antimicrobial compounds50. There are several opportunities for fungi, especially endophytic fungi, to create secondary metabolites, which are important sources of antimicrobial substances with growth-inhibitory effects on phytopathogens and can be employed as biological control agents51,52.
Obviously, results indicate the effect of different applied treatments: T1 [Nematode infection (M. javanica)], T5 [Nematode infection (M. javanica) + Fungus infection (F. solani)], T6 [Nematode infection (M. javanica) + Fungus infection (F. solani) + Overflowed with fungal culture filtrate (P. chrysogenum)], T7 [Nematode infection (M. javanica) + Fungus infection (F. solani) + Overflowed with fungal culture filtrate (Trichoderma spp.)], T13 [Fungus infection (F. solani)] on different anatomical features of okra root, stem and leaves compared with untreated plants (T14) which were evaluated on certain histological features of main okra root, stem and leaf at 60 days after planting. The fungal culture filtrate treatments led to an increase in the number of xylem vessels (NXV) in the vascular bundle. This rise in NXV seemed to be linked to the plant's ability to resist the fusarium wilt disease.Furthermore, the application of fungal culture filtrate resulted in an increase in the quantity and width of the fiber layers, as well as the thickness of the cambium region (Ø) in the root and vascular cylinder. This increase was observed in all the analyzed tissues, except for the cortex layers thickness. In addition, the Ø of the stem and epidermis, mesophyll tissue, and the thickness of vascular bundles (V.B.) in leaves were found to be important defenses against FOC infection, and were positively impacted in plants treated with fungal culture filtrate. Observations in plants treated with fungal culture filtrate revealed the presence of a fresh and regenerated vascular bundle. Pre-treating okra seeds with this filtrate led to beneficial changes in their water-conductive elements, facilitating greater absorption of water by the plants and reducing the spread of wilt disease. In fact, the tracheary components of the xylem, which function as the plant's water-conducting system, play a crucial role in supporting plant growth and development53. These results are consistent with the study of Ahmed and his colleagues on cucumber plants54. Internal root system design can be influenced by a variety of biotic and abiotic stimuli, including bacteria that encourage plant development (PGPM)55; the predominant genera of PGPM are Rhizobia, Acetobacter, Bradyrhizobium, Bacillus, Pseudomonas, Trichoderma56, and Penicillium57. Plant Growth-Promoting Microorganisms (PGPM) mainly induce changes in the architecture of the internal root system and the structure of root tissues by interfering with the plant's phytohormonal balance pathways that regulate cell origination and differentiation58. Several studies have reported that PGPM can provide protection to plants against phytopathogens by inducing the plant's defense mechanisms, which are known as induced systemic resistance (ISR). This phenomenon has been discussed in detail in the review article59. As a result of ISR, the cell wall is strengthened by increased lignin production and callose apposition, which slows the spread of phytopathogens across plant tissues60. As a result of PGPM-induced changes in root architecture and tissue structure, plants are able to absorb water and nutrients more efficiently, leading to faster overall plant development. Moreover, inoculation with P. chrysogenum and Trichoderma spp. can promote plant growth, enhance biomass accumulation, and improve soil nutrient uptake in plants59. A possible defensive mechanism against the okra Fusarium wilt has been suggested by the treatments' increased xylem vessel count and vascular bundle breadth.
Our research results are consistent with those reported by El-Sayed61,who demonstrated that using Trichoderma spp. culture filtrates to treat Faba bean plants against wilt pathogens produced strong evidence of resistance in anatomical examinations. When bioinducers are applied to plants through spraying, histopathological changes occur simultaneously with the elicitation of systemic acquired resistance, which is likely to enhance plant growth compared to unsprayed plants.
Overall, the data obtained clearly show that using fungal filtrates, particularly using fungal filtrate of Penicillium as a spray on plants (T6) or overflowed (T8), play a protective defensive function as resistance-inducers against detrimental effects by improving anatomical performance and metabolic defense system. It was obvious that control plants (nematode infection or fungus infection or both together) were negatively internally affected, which might be due to they not having developed mechanisms by which they protected against biotic stresses.
Conclusion
The present study has shown that the bio-control agents gave good control of the disease complex in okra. The application of [Nematode infection (M. javanica) + Fungus infection (F. solani) + Overflowed with fungal culture filtrate (P. chrysogenum)] and [Nematode infection (M. javanica) + Fungus infection (F. solani) + spray with fungal culture filtrate (P. chrysogenum)] were significantly decreased the reproductive factors in the greenhouse and had the largest impact on nematode galling indices on okra roots. [Nematode infection (M. javanica) + Fungus infection (F. solani) + Overflowed with fungal culture filtrate (P. chrysogenum)] was the most effective medication in this regard, reducing illness severity by (28%) comparatively. On the other hand, the treatment [(Fungus infection (F. solani) + (Dovex 50% fungicide with irrigation water)] had the lowest relative illness severity documented (8%) at that time. The findings demonstrated that all examined anatomical properties of okra root, stem, and leaves were lowered by nematode infection, fungus infection, or nematode infection + fungus infection. Therefore, future studies should be focused on the development of economical and efficient mass production of these bio-agents to be used for the management of this disease complex under Egyptian conditions.
Acknowledgements
The authors thank all the College of Agriculture, Al-Azhar University (branch Assiut) members.
Author contributions
All authors contributed significantly and equally to the conceptualization, writing, editing and review of the current manuscript. All authors agreed to the submission of the current manuscript.
Funding
Open access funding provided by The Science, Technology & Innovation Funding Authority (STDF) in cooperation with The Egyptian Knowledge Bank (EKB).
Data availability
All data available within the article.
Competing interests
The authors declare no competing interests.
Footnotes
Publisher's note
Springer Nature remains neutral with regard to jurisdictional claims in published maps and institutional affiliations.
Contributor Information
Waleed M. Ali, Email: waleed.mohmmed@azhar.edu.eg
Ahmed Fathy Yousef, Email: ahmed.yousuf@azhar.edu.eg.
References
- 1.Habtemariam S, Habtemariam S. Medicinal Foods as Potential Therapies for Type-2 Diabetes and Associated Diseases. Elsevier; 2019. [Google Scholar]
- 2.Patil JA, Kumar A, Yadav S, Verma KK. Nematicidal effect of cruciferous bio-fumigants against the root-knot nematode, infesting okra. J. Nematol. 2020 doi: 10.21307/jofnem-2020-080. [DOI] [PMC free article] [PubMed] [Google Scholar]
- 3.Koenning SR, et al. Survey of crop losses in response to phytoparasitic nematodes in the United States for 1994. J. Nematol. 1999;31:587. [PMC free article] [PubMed] [Google Scholar]
- 4.Mugniéry D, Phillips MS. Potato Biology and Biotechnology 569–594. Elsevier; 2007. [Google Scholar]
- 5.Meena KS, Ramyabharathi SA, Raguchander T, Jonathan EI. Interaction of Meloidogyne incognita and Fusarium oxysporum in carnation and physiological changes induced in plants due to the interaction. SAARC J. Agricult. 2016;14:59–69. doi: 10.3329/sja.v14i1.29576. [DOI] [Google Scholar]
- 6.Thomason, I. J. ChallengesFacingNematology:EnvironmentalRiskswithNematicidesandtheNeedforNewApproaches. (1987).
- 7.Tudi M, et al. Agriculture development, pesticide application and its impact on the environment. Int. J. Environ. Res. Public Health. 2021;18:1112. doi: 10.3390/ijerph18031112. [DOI] [PMC free article] [PubMed] [Google Scholar]
- 8.Sharon E, Chet I, Spiegel Y. Improved attachment and parasitism of Trichoderma on Meloidogyne javanica in vitro. Eur. J. Plant Pathol. 2009;123:291–299. doi: 10.1007/s10658-008-9366-2. [DOI] [Google Scholar]
- 9.Tian X, et al. Suppression of Meloidogyne incognita by the endophytic fungus Acremonium implicatum from tomato root galls. Int. J. Pest Manag. 2014;60:239–245. doi: 10.1080/09670874.2014.958604. [DOI] [Google Scholar]
- 10.Ohwada K. Agar plate method for detection and enumeration of alkylbenzenesulfonate-degrading microorganisms. Appl. Microbiol. 1975;29:40–43. doi: 10.1128/am.29.1.40-43.1975. [DOI] [PMC free article] [PubMed] [Google Scholar]
- 11.Booth C. The Genus Fusarium. Scientific Research Publishing; 1971. [Google Scholar]
- 12.Davet P, Rouxel F. Detection and Isolation of Soil Fungi. Science Publishers Inc; 2000. [Google Scholar]
- 13.Nelson PE, Dignani MC, Anaissie EJ. Taxonomy, biology, and clinical aspects of Fusarium species. Clin. Microbiol. Rev. 1994;7:479–504. doi: 10.1128/CMR.7.4.479. [DOI] [PMC free article] [PubMed] [Google Scholar]
- 14.Leslie JF, Summerell BA. The Fusarium Laboratory Manual. Wiley; 2008. [Google Scholar]
- 15.Ismail MA, Abdel-Hafez SII, Hussein NA, Abdel-Hameed NA. Contributions to the Genus Fusarium in Egypt with Dichotomous Keys for Identification of Species. Tomasz M. Karpiński; 2015. [Google Scholar]
- 16.Hallmann J, Berg G, Schulz B. Microbial Root Endophytes 299–319. Springer; 2006. [Google Scholar]
- 17.Domsch, K. H., Gams, W. & Anderson, T.-H. CompendiumofSoilFungi. Vol. 1. (Academic Press Ltd., 1980).
- 18.Domsch, K. H., Gams, W. & Anderson, T.-H. CompendiumofSoilFungi,2ndTaxonomicallyRevisedEditionbyW.Gams. (IHW, 2007).
- 19.Hussey RS. A comparison of methods of collecting inocula of Meloidogyne spp., including a new technique. Plant Dis. Rep. 1973;57:1025–1028. [Google Scholar]
- 20.Southey, J. F. LaboratoryMethodsforWorkwithPlantandSoilNematodes (1986).
- 21.Hassan, M. H. A. BiologicalControlofCertainPlantDiseasesCausedbySclerotiaProducingFungi (1992).
- 22.Abdel-Razik SA, Sallam NMA, Eraky AMI, Hassan MHA. Integrated control of root rot and wilt disease of faba bean by soil amendment with suppressive compost in combination with seed coating with an antagonistic yeast. Arch. Phytopathol. Plant Protect. 2012;45:1692–1704. doi: 10.1080/03235408.2012.702464. [DOI] [Google Scholar]
- 23.Johanson DV. Plant Microtechnique. McGrow-hill Book Co.; 1940. pp. 27–154. [Google Scholar]
- 24.Gomez KA, Gomez AA. Statistical Procedures for Agricultural Research. Wiley; 1984. [Google Scholar]
- 25.Hossain MM, Sultana F, Kubota M, Koyama H, Hyakumachi M. The plant growth-promoting fungus Penicillium simplicissimum GP17-2 induces resistance in Arabidopsis thaliana by activation of multiple defense signals. Plant Cell Physiol. 2007;48:1724–1736. doi: 10.1093/pcp/pcm144. [DOI] [PubMed] [Google Scholar]
- 26.Sood M, et al. Trichoderma: The "secrets" of a multitalented biocontrol agent. Plants (Basel, Switzerland) 2020 doi: 10.3390/plants9060762. [DOI] [PMC free article] [PubMed] [Google Scholar]
- 27.Tyśkiewicz R, Nowak A, Ozimek E, Jaroszuk-Ściseł J. Trichoderma: The current status of its application in agriculture for the biocontrol of fungal phytopathogens and stimulation of plant growth. Int. J. Mol. Sci. 2022;23:2329. doi: 10.3390/ijms23042329. [DOI] [PMC free article] [PubMed] [Google Scholar]
- 28.Mohiddin FA, et al. Phylogeny and optimization of trichoderma harzianum for chitinase production: Evaluation of their antifungal behaviour against the prominent soil borne phyto-pathogens of temperate India. Microorganisms. 2021;9:1962. doi: 10.3390/microorganisms9091962. [DOI] [PMC free article] [PubMed] [Google Scholar]
- 29.Asad SA. Mechanisms of action and biocontrol potential of Trichoderma against fungal plant diseases—A review. Ecol. Complex. 2022;49:100978. doi: 10.1016/j.ecocom.2021.100978. [DOI] [Google Scholar]
- 30.Bokhari FM. Efficacy of some Trichoderma species in the control of Rotylenchulus reniformis and Meloidogyne javanica. Arch. Phytopathol. Plant Protect. 2009;42:361–369. doi: 10.1080/03235400601070520. [DOI] [Google Scholar]
- 31.Mulusa L. Nematodes-Recent Advances, Management and New Perspectives. IntechOpen; 2021. [Google Scholar]
- 32.Yan Y, et al. Trichoderma harzianum induces resistance to root-knot nematodes by increasing secondary metabolite synthesis and defense-related enzyme activity in Solanum lycopersicum L. Biol. Control. 2021;158:104609. doi: 10.1016/j.biocontrol.2021.104609. [DOI] [Google Scholar]
- 33.Kumar V, Jain RK. Management of root-knot nematode, Meloidogyne incognita by Trichoderma viride, T. harzianum and bacterial antagonist Pseudomonas fluorescens as seed treatment on okra. Indian J. Nematol. 2010;40:226–228. [Google Scholar]
- 34.Arya R. Effect of culture filtrates of Trichoderma viridae and Trichothecium roseum grown on different carbon and nitrogen sources on hatching and mortality of root-knot nematode (Meloidogyne incognita) Indian J. Nematol. 2011;41:62–70. [Google Scholar]
- 35.Javeed MT, Al-Hazmi A. Effect of Trichoderma harzianum on Meloidogyne javanica in tomatoes as influenced by time of the fungus introduction into soil. J. Pure Appl. Microbiol. 2015;9:535–539. [Google Scholar]
- 36.Dababat AA, Sikora RA, Hauschild R. Use of Trichoderma harzianum and Trichoderma viride for the biological control of Meloidogyne incognita on tomato. Commun. Agric. Appl. Biol. Sci. 2006;71:953–961. [PubMed] [Google Scholar]
- 37.d’Errico G, et al. Synergistic effects of Trichoderma harzianum, 1, 3 dichloropropene and organic matter in controlling the root-knot nematode Meloidogyne incognita on tomato. Plants. 2022;11:2890. doi: 10.3390/plants11212890. [DOI] [PMC free article] [PubMed] [Google Scholar]
- 38.Morgan-Jones G, White JF, Rodriguez-Kabana R. Phytonematode pathology: Ultrastructural studies. I. Parasitism of Meloidogyne arenaria eggs by Verticillium chlamydosporium. Nematropica. 1983;3:245–260. [Google Scholar]
- 39.Morgan-Jones, G. & Rodriguez-Kabana, R. Species of Verticillium and Paecilomyces as parasites of cyst and rootknot nematodes. Phytopathology74, 1–28 (1984).
- 40.Sankari Meena K, Ramyabharathi SA, Raguchander T. Biomanagement of nematode-fungus disease complex in Tuberose using plant growth promoting rhizobacteria. Int. J. Sci. Nat. 2016;7:1–9. [Google Scholar]
- 41.Poveda J, Abril-Urias P, Escobar C. Biological control of plant-parasitic nematodes by filamentous fungi inducers of resistance: Trichoderma, mycorrhizal and endophytic fungi. Front. Microbiol. 2020;11:992. doi: 10.3389/fmicb.2020.00992. [DOI] [PMC free article] [PubMed] [Google Scholar]
- 42.Kipngeno P, Losenge T, Maina N, Kahangi E, Juma P. Efficacy of Bacillus subtilis and Trichoderma asperellum against Pythium aphanidermatum in tomatoes. Biol. Control. 2015;90:92–95. doi: 10.1016/j.biocontrol.2015.05.017. [DOI] [Google Scholar]
- 43.Benttoumi N, et al. Diversity of nematode microbial antagonists from Algeria shows occurrence of nematotoxic Trichoderma spp. Plants. 2020;9:941. doi: 10.3390/plants9080941. [DOI] [PMC free article] [PubMed] [Google Scholar]
- 44.Kumar S, Nath R, Kamalwanshi RS. Effect of culture filtrates of different fungi on mobility of second stage juveniles of Meloidogyne incognita. Progress. Hortic. 2010;42:193–197. [Google Scholar]
- 45.Zhang F, et al. Trichoderma harzianum containing 1-aminocyclopropane-1-carboxylate deaminase and chitinase improved growth and diminished adverse effect caused by Fusarium oxysporum in soybean. J. Plant Physiol. 2017;210:84–94. doi: 10.1016/j.jplph.2016.10.012. [DOI] [PubMed] [Google Scholar]
- 46.Ghoniem AA, et al. Enhancing the potentiality of Trichoderma harzianum against Pythium pathogen of beans using chamomile (Matricaria chamomilla, L.) flower extract. Molecules. 2021;26:1178. doi: 10.3390/molecules26041178. [DOI] [PMC free article] [PubMed] [Google Scholar]
- 47.Hegazy MGA, El Shazly AM, Mohamed AA, Hassan M. Impact of certain endophytic fungi as biocontrol agents against sesame wilt disease. Arch. Agric. Sci. J. 2019;2:55–68. doi: 10.21608/aasj.2019.25059.1021. [DOI] [Google Scholar]
- 48.Herrera-Téllez VI, et al. The protective effect of Trichoderma asperellum on tomato plants against Fusarium oxysporum and Botrytis cinerea diseases involves inhibition of reactive oxygen species production. Int. J. Mol. Sci. 2019;20:2007. doi: 10.3390/ijms20082007. [DOI] [PMC free article] [PubMed] [Google Scholar]
- 49.Bastakoti S, Belbase S, Manandhar S, Arjyal C. Trichoderma species as biocontrol agent against soil borne fungal pathogens. Nepal J. Biotechnol. 2017;5:39–45. doi: 10.3126/njb.v5i1.18492. [DOI] [Google Scholar]
- 50.Amaning Danquah C, Minkah PAB, Osei Duah Junior I, Amankwah KB, Somuah SO. Antimicrobial compounds from microorganisms. Antibiotics. 2022;11:285. doi: 10.3390/antibiotics11030285. [DOI] [PMC free article] [PubMed] [Google Scholar]
- 51.Xu K, Li X-Q, Zhao D-L, Zhang P. Antifungal secondary metabolites produced by the fungal endophytes: Chemical diversity and potential use in the development of biopesticides. Front. Microbiol. 2021 doi: 10.3389/fmicb.2021.689527. [DOI] [PMC free article] [PubMed] [Google Scholar]
- 52.Silva DPD, Cardoso MS, Macedo AJ. Endophytic fungi as a source of antibacterial compounds—A focus on Gram-negative bacteria. Antibiotics. 2022;11:1509. doi: 10.3390/antibiotics11111509. [DOI] [PMC free article] [PubMed] [Google Scholar]
- 53.Karam, G. N. BiomechanicalModeloftheXylemVesselsinVascularPlants. Vol. 95 (Oxford University Press, 2005). [DOI] [PMC free article] [PubMed]
- 54.Ahmed, G. A. InductionResistanceofCucumberPlants(CucumissativusL.)AgainstFusariumWiltDiseaseUnderProtectedHousesConditions. (Institute of Plant Protection and Quarantine, Kazakh National Agrarian University, 2011).
- 55.Mohamed HI, El-Beltagi HE-DS, Abd-Elsalam KA. Plant Growth-Promoting Microbes for Sustainable Biotic and Abiotic Stress Management. Springer; 2021. [Google Scholar]
- 56.Saini I, et al. Significance of arbuscular mycorrhizal fungi for Acacia: A review. Pak. J. Biol. Sci. PJBS. 2020;23:1231–1236. doi: 10.3923/pjbs.2020.1231.1236. [DOI] [PubMed] [Google Scholar]
- 57.Hossain MM, Sultana F, Miyazawa M, Hyakumachi M. The plant growth-promoting fungus Penicillium spp. GP15-1 enhances growth and confers protection against damping-off and anthracnose in the cucumber. J. Oleo Sci. 2014;63:391–400. doi: 10.5650/jos.ess13143. [DOI] [PubMed] [Google Scholar]
- 58.Turan M, et al. Plant root enhancement by plant growth promoting rhizobacteria. Plant Roots. 2021 doi: 10.5772/intechopen.99890. [DOI] [Google Scholar]
- 59.De Palma M, Scotti R, D’Agostino N, Zaccardelli M, Tucci M. Phyto-friendly soil bacteria and fungi provide beneficial outcomes in the host plant by differently modulating its responses through (in) direct mechanisms. Plants. 2022;11:2672. doi: 10.3390/plants11202672. [DOI] [PMC free article] [PubMed] [Google Scholar]
- 60.Yu Y, et al. Induced systemic resistance for improving plant immunity by beneficial microbes. Plants. 2022;11:386. doi: 10.3390/plants11030386. [DOI] [PMC free article] [PubMed] [Google Scholar]
- 61.El-Sayed SA. Collaborative potentialities of Trichoderma spp. and Saccharomyces cerevisiae against damping-off and root rot diseases of Faba bean. Egypt. J. Phytopathol. 2022;50:65–78. doi: 10.21608/EJP.2022.134177.1060. [DOI] [Google Scholar]
Associated Data
This section collects any data citations, data availability statements, or supplementary materials included in this article.
Data Availability Statement
All data available within the article.